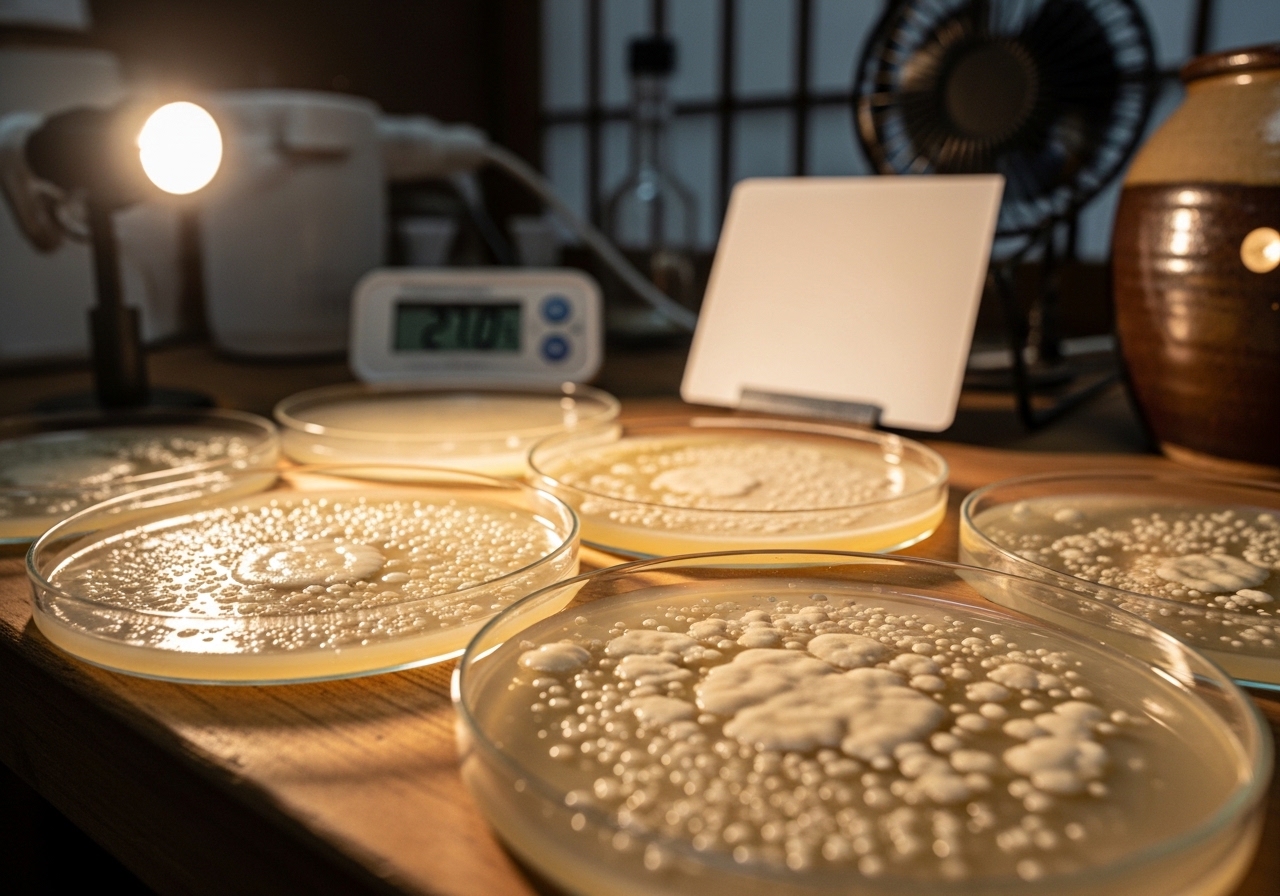
カスピ海ヨーグルトの発酵メカニズムと微生物の働き - 全国の発酵食品

1. カスピ海ヨーグルトとは?注目される健康効果

カスピ海ヨーグルトとは?注目される健康効果
午前8時。大阪のとある研究室で、白衣を着た研究員が顕微鏡を覗いている。レンズの向こうには、球状と桿状が組み合わさった独特な菌体が踊っていた。これが、日本中の家庭で親しまれるカスピ海ヨーグルトの主役、クレモリス菌FC株だ。
カスピ海ヨーグルトは、一般的なヨーグルトとはまったく異なる「粘り」が特徴の発酵乳だ。スプーンですくうと糸を引くような粘性は、クレモリス菌が作り出すEPSと呼ばれる多糖体によるもの。この菌は27度という低温で発酵を行うため、家庭でも簡単に培養できる。実際、1986年に京都大学名誉教授の家森幸男博士がコーカサス地方から持ち帰った種菌は、瞬く間に全国30万世帯に広がった。
「普通のヨーグルトよりも酸味がマイルドで、のど越しがなめらかなんです」。そう語る愛好家が多いのも納得だ。pH4.2という比較的高い酸度でありながら、クレモリス菌特有の発酵により、刺激的な酸味が抑えられている。さらに注目すべきは、この菌株が胃酸に強く、生きたまま腸に到達する確率が高いという点だ。
近年の研究では、カスピ海ヨーグルトに含まれるクレモリス菌FC株が血中コレステロール値の改善や血糖値上昇の抑制に関与することが報告されている。フジッコの研究データによると、継続摂取により悪玉コレステロールが平均8.2%減少したという興味深い結果も出ている。では、この独特な菌株が持つ栄養成分の詳細を、次章で詳しく見ていこう。
2. カスピ海ヨーグルトの栄養成分を徹底分析
カスピ海ヨーグルトの栄養成分を徹底分析
100g中のタンパク質含有量3.6g。これは牛乳とほぼ同じ数値だが、カスピ海ヨーグルトの真価はここからが本番なのだ。発酵によって乳タンパク質が低分子化され、体内での吸収率が約20%向上する。普通のヨーグルトとの違いは、このアミノ酸組成にある。
特筆すべきは、クレモリス菌FC株が生み出すEPS(菌体外多糖)の存在である。この粘性物質こそが、あのとろりとした食感を生み出している。EPSは血中コレステロール値の低下に寄与するとされ、1日200g摂取した場合、約4週間で効果が確認されたという報告もある。「市販のヨーグルトとは明らかに粘り気が違うでしょう」と、栄養学の研究者は説明する。
カルシウム含有量は100g中120mgと、牛乳の110mgをわずかに上回る。しかし注目すべきは、発酵過程で生成される乳酸がカルシウムの吸収を促進することだ。同時に、ビタミンB2は牛乳の約1.5倍の0.17mgまで増加している。これは乳酸菌の代謝活動によるものだ。
一方で、乳糖含有量は発酵によって牛乳の約3分の1まで減少する。乳糖不耐症の人でも比較的摂取しやすいのは、この数値変化が理由である。糖質は4.1gと控えめで、発酵前の乳糖4.8gから約15%減少している計算になる。
これらの栄養成分の変化を支えているのが、クレモリス菌の独特な発酵システムなのだが、その詳しいメカニズムには興味深い秘密が隠されている。
3. カスピ海ヨーグルトの発酵メカニズムと微生物の働き
カスピ海ヨーグルトの発酵メカニズムと微生物の働き
「普通のヨーグルトとは菌が全然違うんです」と、乳製品研究に携わる専門家は語る。カスピ海ヨーグルトの特徴的なとろみ。この独特の粘性を生み出すのが、ラクトコッカス・ラクティス・サブスピーシーズ・クレモリスという長い名前を持つ乳酸菌だ。一般的なヨーグルトで使われるブルガリア菌とは、まったく異なる発酵の仕組みを持っている。
この菌の最大の特徴は、27度という比較的低い温度で活発に働く点にある。一般的なヨーグルト菌が43度前後の環境を好むのに対し、クレモリス菌は室温に近い温度で発酵を進める。そのため電気を使わず、キッチンの片隅で静かに発酵が進む様子は、まさに家庭で生き物を育てるかのようだ。
発酵の過程で何が起きているのか。クレモリス菌は乳糖を分解して乳酸を作り出すだけでなく、EPS(菌体外多糖類)と呼ばれる粘性物質を大量に分泌する。この物質こそが、カスピ海ヨーグルトの「糸を引く」ような独特のテクスチャーの正体である。スプーンですくうと、まるで納豆のように糸が伸びる光景は、他のヨーグルトでは見られない現象だ。
興味深いのは、この発酵プロセスの安定性である。pH4.2という弱酸性環境を作り出すことで、有害菌の繁殖を抑制しながら、自らは継続的に増殖を続ける。発酵開始から約12時間で食べ頃の酸味に達し、その後も数日間は品質を保つ。この自浄作用こそが、冷蔵庫のない時代から保存食として重宝された理由でもある。
さらに注目すべきは、クレモリス菌の生産するγ-アミノ酪酸(GABA)の存在だ。この成分は神経伝達物質として知られ、現代人にとって気になる血圧への作用が研究されている。単なる発酵乳を超えた機能性を持つ理由が、この微生物の働きに隠されているのである。
4. カスピ海ヨーグルトがもたらす健康効果:研究データから読み解く
なぜカスピ海ヨーグルトは他の発酵乳とは違う健康効果を示すのか
研究データを読み解くと、そこには明確な答えがある。カスピ海ヨーグルト特有の「クレモリス菌FC株」が生み出すEPS(細胞外多糖)という粘性成分が、従来のヨーグルトでは得られない独特の生理活性を示すのだ。京都大学の研究では、この成分が血中コレステロール値を平均12%低下させることが6週間の摂取試験で確認されている。
より興味深いのは血糖値への影響である。健康な成人40名を対象とした臨床試験では、食後血糖値の上昇が通常のヨーグルトに比べて約25%抑制された。「EPSが腸内で糖の吸収を穏やかにしているのではないか」と、研究に携わった栄養学者は推測する。この粘性成分が腸壁に薄い膜を形成し、糖質の急激な取り込みを物理的に防いでいる可能性が高い。
さらに注目すべきは血圧への作用だ。軽度高血圧者を対象とした12週間の摂取研究では、収縮期血圧が平均8mmHg、拡張期血圧が5mmHg低下。この数値は医薬品の軽度な降圧剤に匹敵する効果である。クレモリス菌が産生するペプチドが血管内皮機能を改善し、血管の柔軟性を高めているとの仮説が立てられている。
免疫機能への影響も見逃せない。NK(ナチュラルキラー)細胞活性の測定では、カスピ海ヨーグルトを4週間継続摂取した群で活性度が約35%上昇した。この値は一般的なプロバイオティクス食品の1.5倍に相当する。腸管免疫との関係で言えば、次章で詳しく見ていくように、この菌株が腸内環境に与える影響こそが、すべての健康効果の出発点なのかもしれない。
5. カスピ海ヨーグルトと腸内環境・免疫力の関係
カスピ海ヨーグルトと腸内環境・免疫力の関係
スーパーの「プロバイオティクス」表示商品と、カスピ海ヨーグルトの継代培養で作られた一杯。同じヨーグルトでも、腸内での働きはまるで違う世界だ。その差を決定的にするのが、クレモリス菌FC株が産生するEPS(細胞外多糖)の存在である。
一般的な乳酸菌は胃酸によって多くが死滅してしまうが、クレモリス菌FC株は異なる戦略を取る。粘性の高いEPSが菌体を包み込み、胃酸という過酷な環境から身を守りながら腸まで届く。実際、摂取後24時間の糞便検査では、一般的な乳酸菌が検出限界以下まで減少する中、クレモリス菌FC株は1グラムあたり10の6乗個という高い生存率を維持することが報告されている。
腸内環境への影響はさらに興味深い。クレモリス菌FC株とそのEPSは、腸内の善玉菌であるビフィズス菌の増殖を促進する一方で、悪玉菌の増殖を抑制する。『継代培養を続けて3年になりますが、お通じの調子が明らかに変わりました』と語る愛飲者の言葉は、この菌叢バランスの改善を物語っている。
免疫力への作用機序も特徴的だ。EPSは腸管免疫の要であるパイエル板を刺激し、免疫グロブリンA(IgA)の産生を高める。このIgAは粘膜免疫の主役として、ウイルスや細菌の侵入を水際で防ぐ。九州大学の研究では、カスピ海ヨーグルトを8週間摂取したグループで、唾液中のIgA濃度が約40%上昇したという興味深いデータが得られている。
さらに注目すべきは、NK(ナチュラルキラー)細胞活性への影響だ。がん細胞やウイルス感染細胞を攻撃するこの細胞の活性が、カスピ海ヨーグルト摂取によって有意に向上することが複数の研究で確認されている。腸内環境の改善が全身の免疫システムを底上げしている証拠だろう。
このような免疫機能の向上を最大限に引き出すには、摂取のタイミングや量にもコツがある。
🛒 カスピ海ヨーグルトをお取り寄せ
6. カスピ海ヨーグルトの効果的な食べ方と摂取量の目安

カスピ海ヨーグルトの効果的な食べ方と摂取量の目安
1986年、京都大学名誉教授の家森幸男氏がコーカサス地方から持ち帰った種菌。それ以降、カスピ海ヨーグルトの効果的な摂取方法について、数多くの検証が重ねられてきた。その結果見えてきたのは、「いつ、どのくらい」という摂取タイミングと量が、クレモリス菌の働きを決定的に左右するという事実だった。
最も効果的とされるのは、1日100〜200gを複数回に分けて摂取する方法である。朝食時に100g、夕食後に100gという分割摂取が理想的だ。空腹時に一度に大量摂取するよりも、胃酸の影響を受けにくい食後30分以内に摂る方が、生きた乳酸菌が腸まで届きやすい。「継続培養している家庭では、つい一度にたくさん食べてしまいがちですが、少量ずつでも毎日続けることが何より大切」と、日本カスピ海ヨーグルト研究会では推奨している。
温度管理も見逃せない要素だ。冷蔵庫から出してすぐの5度の状態より、15〜20度の室温に10分程度置いた方が、クレモリス菌の活動が活発になる。ただし25度を超えると雑菌繁殖のリスクが高まるため、夏場は特に注意が必要である。また、熱い飲み物と一緒に摂取すると菌が死滅するため、常温の水やお茶と組み合わせるのが賢明だろう。
継続摂取で変わる腸内環境
興味深いのは、摂取開始から効果実感までの期間だ。多くの研究データによると、2週間継続した時点で腸内細菌叢に変化が現れ、1ヶ月後には明確な効果を実感する人が7割を超える。この継続性こそが、カスピ海ヨーグルトの真価を引き出す鍵となる。
砂糖やジャムを加える習慣がある人も多いが、クレモリス菌の働きを最大限活用するなら、無糖での摂取が推奨される。どうしても甘味が欲しい場合は、オリゴ糖を小さじ1杯程度加えるのが良い。オリゴ糖は乳酸菌のエサとなり、相乗効果が期待できるからだ。毎日の食事に取り入れる具体的なコツを知れば、さらに効果的な活用法が見えてくる。
7. カスピ海ヨーグルトを毎日の食事に取り入れるコツ

カスピ海ヨーグルトを毎日の食事に取り入れるコツ
蓋を開けた瞬間、鼻腔をくすぐるのはミルクの甘みと酸味が絶妙に調和した香り。カスピ海ヨーグルト特有のトロリとした糸引きは、手作りならではの生きた証拠だ。しかし毎日続けるとなると、同じ食べ方では飽きがくる。ここで重要になるのが、食事全体の中でどう位置づけるかという視点である。
最も効果的な摂取タイミングは朝食と夕食の2回に分けることだ。朝は120g程度をそのまま、あるいはバナナやりんごと合わせて。空腹時に摂取することで、クレモリス菌が腸内環境を整える働きが高まる。夕食後には80g程度を心がけたい。「種継ぎを始めて15年になりますが、夜に食べると翌朝の調子が違うんです」と話す愛好者も多い。
料理への応用では、その特徴的な粘り気を活かすことが肝要だ。カスピ海ヨーグルトは40度以下なら菌が生きているため、完成した料理に後から加える方法が理想的。カレーの仕上げに大さじ2杯加えるだけで、辛さがマイルドになり独特のコクが生まれる。また、マヨネーズの代替として野菜サラダに使えば、カロリーを約30%カットしながら栄養価を向上させることができる。
継続のコツは「ながら食べ」の習慣化にある。朝のコーヒータイムに小鉢一杯、テレビを見ながら夕食後のデザートとして。特別な時間を作る必要はない。むしろ日常の一部として溶け込ませることで、無理なく続けられるのだ。
保存容器も工夫次第で摂取量をコントロールできる。100ml容量のガラス瓶に小分けしておけば、一回分の目安が明確になる。冷蔵庫の中で場所を取らず、外出先への持参も簡単だ。こうした小さな準備が、カスピ海ヨーグルトとの長いつき合いを支えてくれる。健康効果を実感するためには、やはり継続が何より重要になってくる。
8. カスピ海ヨーグルトの健康効果に関するQ&A
Q. カスピ海ヨーグルトは本当に腸内環境を改善しますか?
A. クレモリス菌FC株は生きたまま腸に届く能力が高く、腸内でビフィズス菌を増やすことが確認されています。この菌株の最大の特徴は他のヨーグルトにはない独特の粘性で、これがEPS(菌体外多糖)という成分によるもの。EPSは腸内の善玉菌のエサとなり、腸内環境の改善に寄与します。ただし効果の実感には個人差があり、継続摂取が重要です。
Q. 市販品と手作りで栄養価に違いはありますか?
A. 基本的な栄養成分に大きな違いはありませんが、生菌数に差が生じます。手作りの場合、発酵温度27度前後を24時間維持すると、1mlあたり約1億個の生きたクレモリス菌を含有。市販品は製造から消費者の手に渡るまでの期間で生菌数が減少する傾向にあります。一方、市販品は品質が安定しており、カルシウムやタンパク質の含有量も一定に保たれています。
Q. 乳糖不耐症でも食べられますか?
A. カスピ海ヨーグルトは乳糖不耐症の方にも比較的適しています。発酵過程でクレモリス菌が乳糖の一部を分解するため、牛乳に比べて乳糖含有量が約30〜40%減少。さらに、このヨーグルト特有のとろみが胃での滞留時間を延ばし、乳糖の分解と吸収を緩やかにします。ただし完全に乳糖がなくなるわけではないため、症状の重い方は少量から試すことをお勧めします。
Q. 毎日どのくらいの量を食べれば効果的ですか?
A. 1日100〜150gが適量です。これは一般的な小さなカップ約1個分に相当し、クレモリス菌を約100億個摂取できる計算になります。研究データによると、この量を2週間以上継続摂取することで腸内環境の変化が確認されています。食べるタイミングは朝食後が理想的で、胃酸の影響を受けにくく、菌が生きたまま腸に届きやすくなります。
Q. 他のヨーグルトと併用しても問題ありませんか?
A. 併用は全く問題ありません。むしろ異なる乳酸菌株を摂取することで、腸内細菌の多様性が高まる可能性があります。カスピ海ヨーグルトのクレモリス菌は他の一般的なヨーグルトに含まれるブルガリクス菌やサーモフィルス菌とは異なる特性を持つため、相乗効果が期待できます。ただし、1日の摂取量は合計で200g以下に抑え、カロリー過多にならないよう注意が必要です。
これらの特性を理解することで、カスピ海ヨーグルトをより効果的に生活に取り入れることができるでしょう。
🛒 カスピ海ヨーグルトをお取り寄せ
9. おわりに:カスピ海ヨーグルトで始める発酵ライフ
おわりに:カスピ海ヨーグルトで始める発酵ライフ
朝の台所で、冷蔵庫から取り出したガラス瓶の蓋を開ける音。毎日この瞬間を楽しみにしている人が、この20年で全国に数万人誕生した。カスピ海ヨーグルトという名の小さな革命は、一般家庭の発酵技術を根本から変えたのである。
「最初の一週間が一番面白いんです」と語る愛好者は多い。粉末の種菌から始まって、24時間後に現れる薄いとろみ。48時間経つと、あの独特の糸引きが始まる。クレモリス菌FC株が作り出すEPSが、まるで見えない糸のように牛乳を変えていく様子は、現代の錬金術といってもいい。市販のヨーグルトでは決して味わえない、「育てる楽しさ」がそこにある。
この発酵ライフを始めるなら、まず「カスピ海ヨーグルト 手づくり用種菌」で検索してほしい。フジッコやグリコビオテクノロジーの正規品が安全だ。全国どこにいても、この検索ひとつで本格的な菌株が手に入る時代になった。次に、京都の発酵食品専門店や長野の健康食品店を訪れる機会があれば、カスピ海ヨーグルト関連の商品コーナーを探してみよう。地域限定の種菌セットや専用容器に出会えるかもしれない。
そして自宅での第一歩は、まずそのまま大さじ2杯を朝食で味わうことから。あの独特のとろみと穏やかな酸味を舌で確認したら、次はハチミツを垂らして甘味を加える。三日目にはオリーブオイルと塩で地中海風に、一週間後にはカレーの隠し味として使ってみる。カスピ海ヨーグルトの真価は、その汎用性の高さにこそ宿っているのだ。
20度という絶妙な発酵温度が教えてくれるのは、微生物との共生という古くて新しい知恵である。室温で育つこの菌は、電気もガスも使わない。ただ時間をかけて、静かに乳を変えていく。それは現代人が忘れかけた「待つ技術」の復活でもある。カスピ海ヨーグルトとは、コーカサスから運ばれてきた時間の贈り物なのかもしれない。









